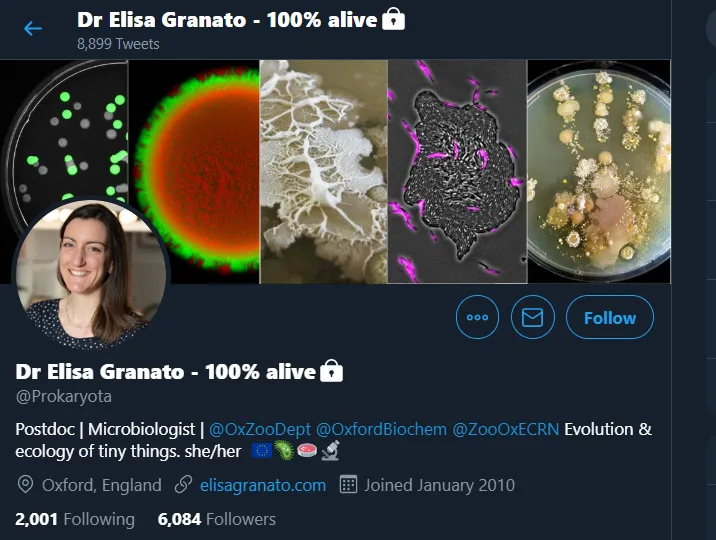
117291035_780238202733882_947486952482829163_n

Mga Ka-Sampaguita, tunay at sadyang naiinis ako sa mga nagpapakalat ng fake news. Kaya nga, paulit-ulit natin...
Ramon Ignacio
Mga Ka-Sampaguita, sadyang lason sa utak ang mga maling balita o fake news. Paulit-ulit tayong pinaalalahanan ng...
Bagama’t nasa krisis tayo dahil sa COVID-19 pandemic,hindi lang dapat tayo nakatutok sa paglaban dito. Huwag nating...
Ang buwan ng Agosto ay tunay na buwan ng wika. Sa darating na petsang 19, gugunitain natin...
Matapos sitahin at aksyunan ang tungkol sa violations ng ABS-CBN mga Ka-Sampaguita, sinisiyasat na rin ng Kamara...
Tunay na pahirap sa sangkatauhan ang pangglobong salot na COVID-19, mga Ka-Sampaguita. Habang naglalakbay tayo sa mundong...
Sadyang nakalalason ng isipan ang mga fake news, mga minamahal kong mga Ka-Sampaguita. Kapag agad kang naniwala,...
Ngayong wet season at madalas lagi ang pag-ulan, mahalagang malinis ang mga daluyan ng tubig. Sa gayun...
Muli, isa na naman pong magandang araw sa inyo, mga minamahal kong mga kababayan. Mga ginigiliw kong...
Muli, isa na naman pong magandang araw sa inyo, mga minamahal kong mga kababayan. Mga ginigiliw kong...